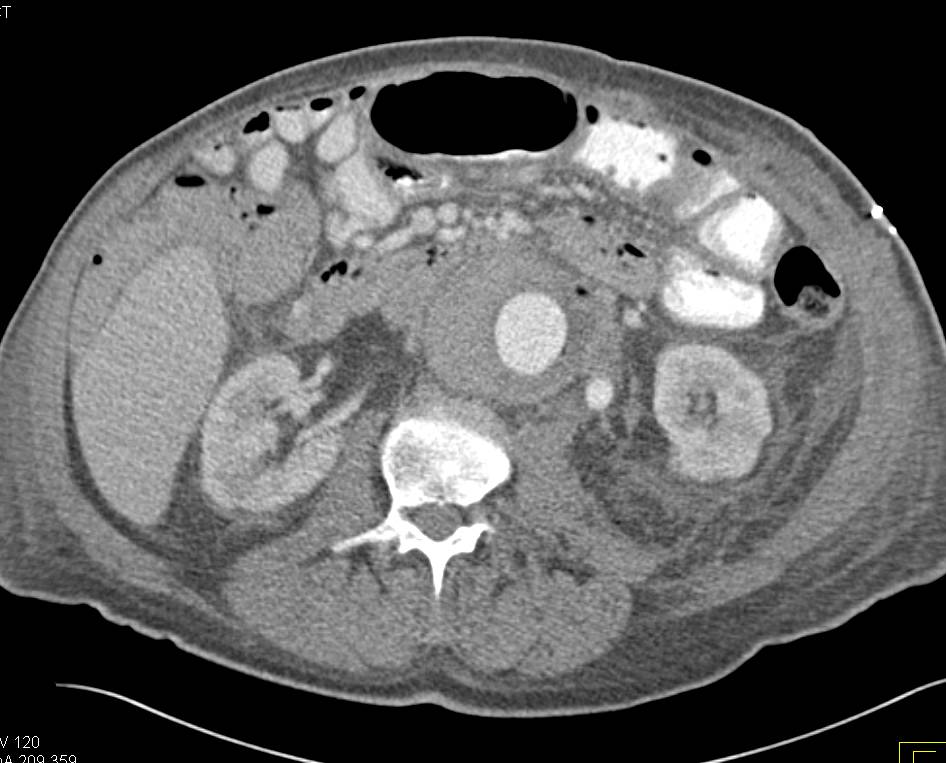

- 6
- 8
- ,
- 0
- 0
- 6
To Quiz Yourself: Select OFF by clicking the button to hide the diagnosis & additional resources under the case.
Quick Browser: Select ON by clicking the button to hide the additional resources for faster case review.
CASE NUMBER
4,677
Diagnosis
Aortic Aneurysm with Aorto-Enteric Fistulae. Note the Air in the Aortic Sac.
THIS IS CASE
4,677
OF
8,707